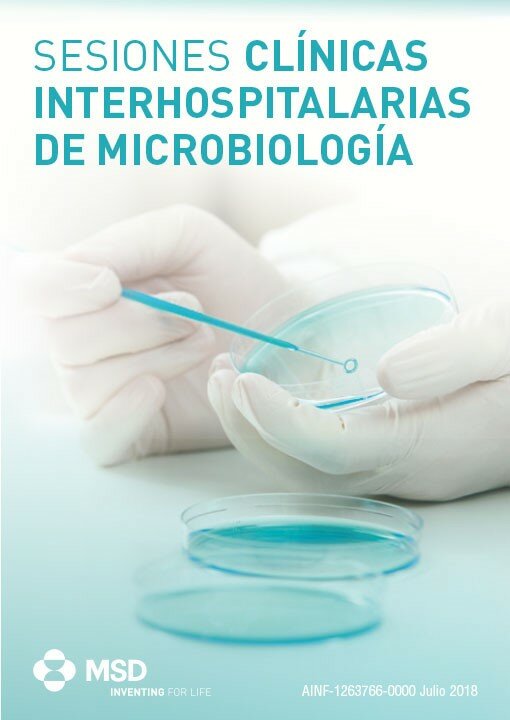

Protocolos, catálogos, documentos científicos
Protocolos
- Protocolo de actuación frente a casos sospechosos de enfermedad por virus ébola (EVE). Andalucía, 16 de junio de 2015.
- Procedimiento de actuación frente a casos de infección por el nuevo coronavirus (MERS-CoV). España, 11 de febrero de 2015.
- Protocolo de vigilancia de la enfermedad por virus Chikungunya. Andalucía, 4 de julio de 2014.
- Guía de procedimientos para la Vigilancia de la gripe en España, mayo 2014
- Directrices para el envío de especímenes a los laboratorios clínicos para el diagnóstico biológico.
- Plan de Vigilancia de Gripe de Andalucía 2012-2013
- Diagnóstico de laboratorio de meningitis y encefalitis víricas. Protocolo del laboratorio de referencia.
- Protocolo del laboratorio de referencia de salud pública para enfermedades con sospecha de etiología vírica.
- Plan de acción para la eliminación del sarampión en Andalucía, 2014.
- Protocolo de actuación ante alertas por parotiditis.
- Protocolo de Vigilancia Epidemiológica Parálisis Fláccida Aguda.
- Protocolo de vigilancia de la rubéola y del síndrome de rubéola congénita. Adaptación del protocolo de la Red Nacional de Vigilancia a Andalucía.
- Procedimientos actualizados del CNM para la caracterización de Neisseria meningitidis [r1]. 2011
- Manual de obtención y manejo de muestras para el laboratorio clínico, Servicio Andaluz de Salud, 2009
- Recomendaciones sobre la higiene de manos y uso correcto de guantes en centros sanitarios. 2005
- Medidas de control para la prevención de las infecciones hospitalarias en intervenciones quirúrgicas. SAS
- Plan de vigilancia y control de las infecciones nosocomiales en los hospitales del Servicio Andaluz de Salud. 2002
Protocolos SAMPAC
- Coprocultivo
- Exudados
- Hemocultivo
- Infecciones vaginales
- Líquido cefalorraquídeo
- Tracto respiratorio inferior
- Tracto respiratorio superior
- Urocultivo
Catálogos
- Catálogo URVs. Laboratorio clínico. 2009
- Laboratorios de referencia de micobacterias del Sistema Sanitario Público de Andalucía. 2009
Documentos científicos
-
Documento de consenso de evaluación de la equivalencia clínica de las carbapenemas.2012
(Autores: representantes de diferentes Sociedades científicas andaluzas). -
Documento de consenso sobre posibles equivalentes terapéuticos en equinocandinas. 2012
(Autores: representantes de diferentes Sociedades científicas andaluzas). - Recomendaciones para el diagnóstico en Microbiología Clínica, Servicio Andaluz de Salud. 2001
- Información relacionada con el envío de muestras a distintos laboratorios de referencia (CNM y laboratorios de referencia Autonómicos), Consejería de Salud, Junta de Andalucía. 2011
- Guía terapéutica antimicrobiana del área del Aljarafe 2011
- Programa PIRASOA 2013
- Grupos de trabajo de la SAMPAC 2014
Formularios
Otros documentos
-
Documentos científicos SEIMC
(Procedimientos microbiológicos, protocolos clínicos, guías clínicas, etc)